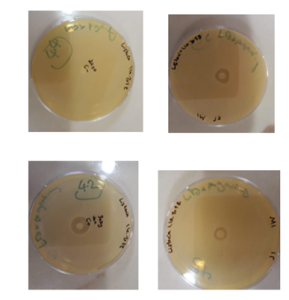

الخلفية وهدف البحث: تُعد مقاومة الجراثيم للمضادات الحيوية من أبرز التحديات الصحية العالمية، الأمر الذي يدفع إلى البحث عن بدائل علاجية فعالة وآمنة. ومن بين هذه البدائل، برزت الببتيدات المضادة للميكروبات بفضل آليات تأثيرها غير التقليدية. يُعد ببتيد الإيومينيتين، المستخلص من زعاف أحد أنواع الدبابير الانفرادية، من المركبات الواعدة ذات النشاط البيولوجي المتعدد. يهدف هذا البحث إلى إنتاج ببتيد الإيومينيتين المؤشب باستخدام تقنيات الهندسة الوراثية وتقييم فعاليته الحيوية ضد سلالات جرثومية موجبة وسالبة الغرام.
مواد البحث وطرائقه: تم تحديد تسلسل الحموض الأمينية لببتيد الإيومينيتين باستخدام قاعدة بيانات GenBank، وتصميم المسابير الجينية عبر برنامج Geneious لاستهداف الجين المسؤول عن التعبير. جرى استنساخ الجين ودمجه مع البروتين الفلوري الأخضر (GFP) والتعبير عنه في بكتيريا Escherichia coli تم التأكد من نجاح التنسيل والتعبير من خلال تحليل تسلسل الحمض النووي للبلاسميد. كما تم تقييم كفاءة التنقية باستخدام مطيافية التألق واختبارات تركيز البروتين. قيّمت الفعالية المضادة للجراثيم للببتيد المنتج باستخدام اختبار كيربي-باور ضد سلالات موجبة الغرام (Staphylococcus aureus وListeria monocytogenes) وسالبة الغرام.(Salmonella enterica , Yersinia enterocolitica).
النتائج :أظهرت النتائج نجاح إنتاج ببتيد الإيومينيتين المؤشب واحتفاظه بفعاليته الحيوية، حيث لوحظت مناطق تثبيط واضحة حول الأقراص المعالجة بالببتيد، مما يدل على نشاطه المضاد للجراثيم ضد السلالات المختبرة.
الاستنتاجات: تؤكد الدراسة إمكانية إنتاج ببتيد الإيومينيتين بكفاءة وبتكلفة منخفضة عبر تقنيات الهندسة الوراثية، مما يوفر بديلاً واعداً للببتيدات المعزولة طبيعياً أو المصنعة كيميائياً. وتشير النتائج إلى إمكانية تطوير الإيومينيتين كدواء مضاد للجراثيم يُسهم في مواجهة مقاومة المضادات الحيوية.
المقدمة Introduction
تُعد مقاومة الجراثيم للمضادات الحيوية من أخطر التحديات الصحية العالمية في القرن الحادي والعشرين، وصفتها منظمة الصحة العالمية بأنها تهديد رئيسي للصحة عالمياً، مما يتطلب تحركاً فورياً لتطوير بدائل علاجية فعالة وآمنة [1]. وقد أشار تقرير حديث نشرته مجلة The Lancet Infectious Diseases بالتعاون مع المنظمة إلى أن عام 2024 شهد أكثر من 4.95 مليون حالة وفاة مرتبطة بعدوى مقاومة، منها 1.27 مليون حالة وفاة نُسبت مباشرة إلى المقاومة البكتيرية [2].
ولا تقتصر تداعيات هذه الظاهرة على الجانب السريري فحسب، بل تمتد إلى النواحي الاقتصادية، حيث تسهم في ارتفاع تكاليف الرعاية الصحية، وزيادة الأعباء على الأنظمة العلاجية نتيجة فشل العلاجات التقليدية والحاجة إلى أدوية أكثر تكلفة. في مواجهة هذا التحدي، ظهرت الببتيدات المضادة للميكروبات (Antimicrobial peptides, AMPs) كبدائل واعدة بفضل آليات تأثيرها غير التقليدية، والتي تقلل من فرص تطوير المقاومة ضدها [3]. وتنتمي هذه الببتيدات إلى الجهاز المناعي الفطري في كائنات حية مختلفة، وتمتاز ببنية خطية بسيطة ونشاط واسع الطيف، إذ تعمل عبر إحداث خلل في سلامة الغشاء الخلوي الجرثومي، مما يؤدي إلى اختلال التوازن الأيوني وموت الخلية [4].
ضمن هذا الإطار، لاقت السموم الحيوانية اهتماماً متزايداً كمصدر طبيعي غني بالببتيدات ذات الفعالية المضادة للجراثيم، والتي أثبتت فعاليتها في مواجهة العديد من الكائنات الممرضة المقاومة. وعلى سبيل المثال لا الحصر تم توثيق عدد من هذه الببتيدات في سموم الحشرات كالنحل والدبابير، حيث أظهرت نشاطاً ميكروبياً مميزاً وخصائص دوائية واعدة. أظهر زُعاف النحل (Apis mellifera) فعالية مضادة لطيف واسع من الجراثيم، خصوصاً موجبة الغرام، بفضل مكوناته الببتيدية مثل Melittin، Apamin، MCD، وPhospholipase A2 (PLA2)، مما يدعم استغلاله كمصدر طبيعي لتطوير مضادات حيوية جديدة [5]. يُصنف ببتيد الميليتين ذو البنية الخطية والوزن الجزيئي المنخفض من الببتيدات القاتلة للميكروبات (AMPs) عبر آلية اختراق الأغشية الخلوية، وقد أظهرت دراسة منشورة في مجلة Amino Acids أن مشتقاته المصممة أظهرت فعالية ملحوظة ضد البكتيريا المقاومة للأدوية، مع تقليل السُمية وتحسين الاستقرار البيولوجي، مما يجعله مرشحًا قويًا للعلاج الموضعي أو أنظمة النقل النانوي [6].
أثبتت تقنية التعبير المؤشب، وبشكل خاص في نظام E.coli، فعاليتها كأحد ركائز التقانة الحيوية الحديثة في إنتاج البروتينات العلاجية [7]. ويكتسب هذا النهج أهمية متزايدة، لا سيما في ظل صعوبة استخلاص الببتيدات ذات الوزن الجزيئي المنخفض من مصادرها الطبيعية بكميات كافية وكلفة اقتصادية [8].وقد أُنتجت باستخدام هذا النظام ببتيدات دوائية عالية الفعالية مشتقة من سموم حيوانية، مثل Eptifibatide (Integrilin®) وTirofiban (Aggrastat®)، وكلاهما يُستخدم سريريًا كمثبط لتكدس الصفيحات الدموية، وقد تم تطويرهما من بروتينات موجودة في سم الأفاعي [9]. وبالاستفادة من النجاحات المسجلة في تحويل مكونات السموم الحيوانية إلى أدوية مبتكرة عبر أنظمة التأشيب، تزايد الاهتمام بدراسة مركبات جديدة ذات نشاط ميكروبي محتمل يمكن إنتاجها مخبرياً بكفاءة وبتكلفة منخفضة.
وفي السياق ذاته، يُعد الإيومينيتين (Eumenitin) ببتيداً كاتيونياً خطياً مكوناً من 15 حمضًا أمينيًا (ILGTILGLLKGLGVF) وهو أحد المكونات البروتينة لزُعاف دبور Eumenes rubronotatus. ويتخذ هذا الببتيد بنية حلزونية ويمتاز بخواص محبة للماء والدسم معًا (Amphiphilic properties)، ويُظهر نشاطًا ضد مجموعة من الجراثيم موجبة وسالبة الغرام، بالإضافة إلى تأثير متوسط ضد طفيلي اللاشمانيا ونشاط محفز في الخلايا البدينة (Mast cell degradation) وقد بيّنت الدراسات أن الإيومينيتين يتمتع بهامش أمان جيد، إذ لم يُحدث انحلالًا في كريات الدم الحمراء ضمن التركيزات الفعالة. وتعتمد آلية عمل الإيومينيتين على نموذج “الثقب الحلقي(Toroidal pore)، حيث يتفاعل مع الليبيدات في الغشاء الخلوي لتكوين قناة مستمرة، ما يؤدي إلى اختلال نفاذية الغشاء دون استهداف بروتينات محددة، مما يُصعّب على الجراثيم تطوير مقاومة وراثية فعالة [10].
في هذه الدراسة، تم إنتاج ببتيد الإيومينيتين (Eumenitin) بطريقة التأشيب في E.coli، لتقييم فاعليته المضادة للجراثيم بهدف التحقق من مدى كفاءة إنتاجه واحتفاظه بفعاليته الحيوية، مما كمونه العلاجي المضاد للجراثيم في المستقبل.
المواد والطرائق Materials and Methods
إنتاج وتنقية ببتيد الإيومينيتين المؤشب
إنتاج الببتيد المؤشب
استخدمت السلالة البكتيرية E. coli Top10 في خطوات تنسيل الجين، بينما استُخدمت السلالة E. coli BL21 (Gold) في التعبير البروتيني. ولغرض تنسيل جين الديكورالين والتعبير عنه، تم استخدام بلاسميدات مُصممة مسبقًا وهي بلاسميد التعبير البروتيني pRSET (Invitrogen) والبلاسميد المشتق عنه pRSET-sfGFP، حيث جرى إدخال الجين الهدف باستخدام برنامج Geneious [11]. واختير البلاسميد التجاري pRSET (Invitrogen) لاحتوائه على محفز T7 عالي الكفاءة ووسمة سداسية الهستيدين (His₆-tag) عند النهاية الأمينية، مما يسهل عملية تنقية البروتين لاحقًا. كما استُخدم بلاسميد مشتق هو pRSET-sfGFP متوفر في هيئة الطاقة الذرية، يتضمن تسلسل البروتين الفلوري الأخضر الفائق (sfGFP)، كواسم لتتبع التعبير البروتيني وتحسين طيّ البروتين داخل الخلية.نُميت السلالات البكتيرية في وسط Luria-Bertani (LB)، بينما استخدم وسط Yeast Tryptone (2YT) أثناء تهيئة الخلايا، واستخدم أثناء تحوير الخلايا وسط (SOB) Super Optimal Broth هو وسط غذائي يُستخدم بشكل أساسي لتحضير الخلايا البكتيرية الكهروضوئية، لاحتوائه على مكونات تدعم نمو الخلايا وتحسين كفاءتها في التحوير. أضيف المضاد الحيويCarbenicillin بتركيز مناسب لضمان انتقاء السلالات المحوّرة المقاومة له، وتم تحضين الزرعات عند 37°م طوال الليل.
صُمم جين ببتيد الإيومينيتين (Eumenitin) بناءً على تسلسل الأحماض الأمينية المستخلص من البنية الفراغية للبروتين المرجعي المسجل في قاعدة بيانات PDB (ID: 2N9A, Chain A)، وقد تم تحسين الكودونات لتتلاءم مع نظام التعبير في E. coli بهدف رفع كفاءة الترجمة [12]. جرى تجميع التسلسل باستخدام تقنية One-pot assembly من oligonucleotides مصممة خصيصًا من مسبرين متتامين الجدول (1)، مع إدراج مواقع إنزيمات التقييدApaI وHindIII، بالإضافة إلى موقع إنزيم TEV protease ووسمة- Tag .His6

تم تضخيم الشدفة الجينية عبر مرحلتين من تفاعل البلمرة المتسلسل (PCR)، حيث حُضِّر حجم نهائي قدره µl 25 يحتوي على µM 0.5 من كل مرئسة ضمن الشروط الآتية: 4 دقائق في 94°م، ثم 35 دورة (30 ثانية في 94°م، 30 ثانية في 60°م، و30 ثانية في 72°م)، مع 7 دقائق في 72°م. شملت تفاعلًا أوليًا لإنتاج قالب أولي يمثل شدفة الإيومينيتين، أعقبه تفاعل بلمرة متعاقب (Nested PCR) باستخدام بادئين مستمدين من تسلسل البلاسميد الحاوي على الجين. ولتحقيق دقة عالية، استُخدم إنزيم بلمرة عالي الدقة (High-fidelity DNA polymerase) بتركيز U 1.25 لتقليل نسبة الأخطاء الناتجة عن الاستنساخ الشكل (1).

تم إجراء التحوير البكتيري Bacterial transformation بالتخريم الكهربائي ل سلالة E. Coli Top 10 في مرحلة التنسيل. اعتمدت هذه الطريقة لأنها أقل تعقيداً وأكثر فعالية من الطريقة الكيميائية إذ تعتمد على زيادة نفاذية الغشاء السيتوبلاسمي للخلية وإمكانية إحداث ثقوب فيه عن طريق تطبيق حقل كهربائي عالي الفولطية وبالتالي إمكانية عبور الدنا المشحون سلباً لداخل الخلية. وقد تم تهيئة الخلايا قبل استخدامها في عملية التحوير البكتيري لرفع حيويتها وكفاءتها، بغسلها لتخليصها من الأملاح والفضلات الناتجة عن تغذيتها وحفظها بمواد حاوية على مصدر كربوني [13].
استعمل الرحلان الكهربائي على هلامة الأغاروز بتركيز 1.5% لتحديد أطوال شدف الدنا DNA وقد تم استخدام واسم أطوال معيارية (100 bp DNA ladder، Promega) يتراوح بين 100–1500 زوج قاعدي لتقدير أطوال شدف الدنا بدقة. تم تنقية ناتج تفاعل PCR بعد الترحيل باستخدام الطاقم Wizard SV gel and PCR clean – Up system (promega) kit، ثم أُدرجت الشدفة في بلاسميد التعبير pRSET-sfGFP..
تمت عملية التعبير البروتيني وفقًا لدراسة Sambrook وآخرون [14]، فبعد تحوير خلايا E. coli BL21 (Gold) بالبلاسميد pRSET-sfGFP باستخدام الصدمة الحرارية، زُرعت المستعمرات المختارة في وسط (LB) يحوي على المضاد الحيوي كاربنسيلين. عند وصول النمو البكتيري إلى كثافة ضوئية (OD600 ≈ 0.6)، تم تحفيز التعبير البروتيني بإضافة IPTG بتركيز 0.3 مليمول/لتر، مع متابعة التحضين عند 28°م لمدة 16 ساعة.
جُمعت العينات في ثلاث نقاط زمنية (T0، T6، T16) لتقييم مستويات التعبير البروتيني، وذلك بثلاث مكررات مستقلة لضمان الدقة الإحصائية. جرى تحليل مستويات التعبير باستخدام الرحلان الكهربائي للهلام (SDS-PAGE)، وصُبغت البروتينات بصبغة Coomassie Brilliant Blue لتوضيح العصابات البروتينية. كما جرى التحقق من صحة الإدخال والتعبير باستخدام جهاز Genetic Analyzer System ABI 310 في هيئة الطاقة الذرية السورية – قسم التقانة الحيوية، مع مرئسات نوعية GFP-F/T7R.

تنقية الإيومينيتين المؤشب
تم تنقية الأيومنتين المؤشب باستخدام تقنية كروماتوغرافيا الإلفة المعدنية (METAL Affinity Chromatography)، بالاعتماد على وجود الوسمة سداسية الهستيدين(His-tag6x). تم تنفيذ عملية التنقية باستخدام جهاز AKTA Prime System المتوافر في هيئة الطاقة الذرية، حيث تم تحميل الخلاصة البكتيرية المحتوية على الإيومنيتين المؤشب على عمود Ni-NTA (Qiagen المشحون بأيونات النيكل بسعة .5 ML
اعتمدت آلية التنقية على الارتباط التفضيلي بين الوسمة الهيستيدينية وأيونات النيكل المرتبطة بالراتنج، بينما أُزيلت البروتينات غير المرتبطة باستخدام دارئة ذات تركيز منخفض من الإيميدازول (دارئة الربط). وتم فصل البروتين الهدف باستخدام دارئة شطف ذات تركيز عالٍ من الإيميدازول، بما يسمح بتحرير الإيومنيتين من العمود.
لاحقًا، تم تتبع وجود البروتين الفلوري وتقدير التعبير باستخدام جهاز Fluoroskan Ascent (Thermo Scientific)، وذلك عند أطوال موجية (إثارة: 485 نانومتر / انبعاث: 538 نانومتر)، بما يتماشى مع الخصائص التألقية للبروتين الفلوري الأخضر. جرى تحديد تركيز البروتين المنقّى باستخدام طريقة Bradford، والتي تعتمد على ارتباط صبغة Coomassie Brilliant Blue بالبروتينات وحدوث انزياح طيفي في الامتصاص يقاس عند طول موجي 595 نانومتر. وقد تم إنشاء منحنى معياري باستخدام تراكيز مختلفة من ألبومين مصل البقر (BSA) كمادة مرجعية، ومن ثم حساب تراكيز العينات المدروسة بالمقارنة مع المنحنى المعياري [15]. تم تحليل البروتين الناتج باستخدام الرحلان الكهربائي SDS-PAGE على هلامة بولي أكريلاميد 15% مقارنةً بواسم بروتين معياري.
اختبار الفعالية المضادة للجراثيم
العزلات البكتيرية
تم استخدام أربع سلالات بكتيرية معيارية لتقييم الفعالية المضادة للجراثيم للببتيد المؤشب، وقد شملت السلالات جراثيم إيجابية الغرام مثل Staphylococcus aureus (ATCC 25923) وListeria monocytogenes (ATCC 19115)، بالإضافة إلى جراثيم سلبية الغرام ممثلة بكل من Salmonella enterica (ATCC 14028) وYersinia enterocolitica (ATCC 9610). جرى الحصول على هذه السلالات من المجموعة الأمريكية لزراعة الخلايا (ATCC)، وتم حفظها في درجة حرارة –80°C ضمن وسط غذائي مدعّم بنسبة 20% من الغليسرول إلى حين استخدامها.
اختبار كيربي-باور للانتشار بالقرص (Kirby-Bauer Disk Diffusion Assay)
تم تقييم الفعالية الحيوية للببتيد المؤشب باستخدام اختبار كيربي-باور بطريقة الانتشار بالقرص، وذلك وفقًا للإرشادات الصادرة عن معهد المعايير السريرية والمخبرية (CLSI) جرى تحضير وسط مولر-هينتون الآغار (Müller-Hinton Agar, MHA) وفق تعليمات الشركة المصنّعة، ثم صُب في أطباق بتري بسماكة متجانسة تبلغ نحو 4 مم، بما يتوافق مع المعايير المعتمدة [16]. تمت زراعة مستعمرات مفردة من كل سلالة بكتيرية في أنابيب تحتوي على وسط مولر-هينتون السائل، ثم حُضنت عند درجة حرارة 37°C لمدة 18 ساعة مع التحريك المستمر. بعد الحضانة، تم قياس عكارة المعلقات البكتيرية باستخدام جهاز المطياف الضوئي (spectrophotometer) على طول موجه 600 نانومتر، وذلك لضبط الكثافة البكتيرية بما يتوافق مع McFarland standard 0.5، والذي يعادل تقريبًا 1.5×10⁸ وحدة تشكيل مستعمرة لكل مليلتر(CFU/mL) .
تم تلقيح سطح وسط الآغار المحضّر مسبقًا باستخدام مسحة معقّمة مغموسة في المُعلّق البكتيري المعيّر، ثم تُركت الأطباق لتجف تحت ظروف معقمة. وُزعت بعد ذلك أقراص ورقية معقمة بقطر 6 مم، حيث تم تشبيع كل قرص بـ 20 ميكروغرامًا من الببتيدالمؤشب.
تضمنت الدراسة خمس مجموعات نُفذت بثلاثة مكررات لكل مجموعة لضمان الدقة الإحصائية. شملت هذه المجموعات: أقراص مشبعة بدارئة الحل فقط كمجموعة شاهد سلبي، أقراص تحتوي على كاربنسلين كمضاد مرجعي للجراثيم إيجابية الغرام، أقراص تحتوي على فانكومايسين كمضاد مرجعي للجراثيم سالبة الغرام، وأقراص مشبعة بالببتيد المؤشب بتركيز 40 µM قيد التقييم، ومجموعة الشاهد المعياري بتركيز 40 µM وهو الأيومنيتين الخام من شركة NovoPro Bioscience Inc.
أُدخلت الأطباق إلى الحاضنة عند درجة حرارة 37°م للمدة 24 ساعة. ثم تم قياس أقطار مناطق تثبيط النمو وتم تحليل النتائج لتحديد الفعالية المضادة للبكتيريا للمركب المدروس.
التحليل الاحصائي
تم تحليل البيانات باستخدام برنامج SPSS الإصدار 26، وذلك باعتماد اختبار تحليل التباين الأحادي (One-way ANOVA) متبوعًا باختبار توكي للمقارنات البعدية (Tukey’s post-hoc test) لتحديد الدلالة الإحصائية بين المجموعات، باعتبار قيمة P < 0.05 مؤشرًا على فرق معنوي إحصائي.
النتائج Results
إنتاج الببتيد المؤشب
تم التحقق من نجاح إدخال جين Eumenitin المصمم صناعيًا إلى نظام التعبير البكتيري E. coli عبر عدة مراحل.أظهرت النتائج الأولية لتفاعل البوليميراز المتسلسل (PCR) للمستعمرات المحوّرة شريطًا واضحًا على الهلام الكهربائي عند حجم يقارب 286 زوجًا قاعديًا، وهو ما يتوافق مع الحجم المتوقع للقطعة المُستهدفة (الشكل 3).

الشكل (3): تفاعل PCR على مستعمرات بكتيرية باستخدام البادئات T7F/T7R بعد تحويل خلاياE. Coli ببلازميد pRSET-sfGFP. تم تحليل نواتج PCR على هلام أغاروز بتركيز 1.5%. استُخدم واسم أطوال معيارية (100 bp DNA ladder، Promega) بمدى 100–1500 bp. يُظهر البئر (1) الشاهد السلبي (البلازميد فقط) دون ظهور شريط بالحجم المتوقع، بينما يُظهر البئر (2) شدفة الإيومينيتين بالحجم المتوقع (bp~286)
عزز تحليل التقطيع الإنزيمي للبلازميد المؤشب هذه النتيجة، حيث أظهرت العينات المحلّلة حزمة مميزة بالحجم المتوقع بعد الهضم باستخدام إنزيمي ApaI وHindIII، مما يشير إلى اكتمال عملية الإدخال الجيني. الشكل (4)

الشكل (4): حزمة الإيومنيتين المؤشب بالحجم المتوقع 1085 ~bp بعد الهضم باستخدام إنزيمي ApaI و.HindIII
كما بيّن تحليل تسلسل الدنا (DNA sequencing) تطابقًا كاملًا بنسبة 100% بين تسلسل الجين المُدخل والتسلسل المُصمم بعد تحسين الكودونات، دون وجود أي طفرات نقطية أو حذف، مما يؤكد دقة الإدخال وموثوقيته. تم تتبّع التعبير المؤشب لبنية Eumenitin-sfGFP في خلايا E. coli من نمط BL21 (Gold) بعد التحريض باستخدام مادة IPTG، وذلك بالاعتماد على البروتين الفلوري الأخضر (GFP) المُدمج كمُعلم بصري. لوحظ توهّج فلوري أخضر واضح في المستعمرات المحرّضة بعد فترة حضن استمرت 16 ساعة عند درجة حرارة 28 °م، مما يدل على نجاح التعبير البروتيني المستهدف ويؤكد كفاءة نظام التعبير المستخدم. يبين الشكل (5) الرحلان الكهربائي (SDS-PAGE) أنه بعد مرور 16 ساعة على تحريض IPTG البئر (4)، لوحظ تعبير ملحوظ لبروتين sfGFP-Eumenitin بوزن جزيئي 38 كيلودالتون في حين لم يتم التعبير عنه عند الزمن 0 البئر (3) و نلاحظ بدء التعبير بعد 6 ساعات البئر (2).

الشكل (5): هلامة عديد الأكريلاميد بتركيز 15%، المصبوغة بصبغة الكوماسي الزرقاء. يمثل البئر M الواسم المعياري للبروتينات، البئر3 (T0) يمثل خلاصة البكتيريا قبل التحريض، البئر 4 (T16) يحتوي على خلاصة البكتيريا بعد 16 ساعة من التحريض، وتُبينر ظهور عدة عصابات، من بينها عصابة تقارب وزنها الجزيئي 38kDa لبروتين المستهدف بدون تنقية، نلاحظ في البئر 2(T6) اثر للبروتين بعد 6 ساعات من التحريض دليل بدء عملية التعبير البئر 1 مكرر لعينة T6.
تنقية الإيومنيتين المأشوب
تم استخلاص البروتين المنتج في خلايا البكتيريا من السيتوبلازم بعد 16 ساعة من التحريض، تلا ذلك تنقية البروتين المؤشب DECO-sfGFP باستخدام عمود كروماتوغرافيا الإلفة المعدنية المشحون بأيونات النيكل على جهاز AKTA Prime System. أتاح كاشف الأشعة فوق البنفسجية (UV) المدمج في هذا النظام المراقبة الفورية والمباشرة لجميع مراحل عملية التنقية (الشكل 6) و جمع البروتين المؤشب.

الشكل (6): تنقية البروتين المأشوب Eumen-sfGFP بعمود كروماتوغرافيا الإلفة الشاردية لشوارد النيكل.
تم تحليل البروتين المنقى باستخدام تقنية SDS-PAGE لوحظ وجود عصابة بروتينية واضحة عند وزن جزيئي يُقدّر بحوالي 38 كيلودالتون، أظهر تحليل SDS-PAGE عصابة بروتينية بالحجم ~38 كيلودالتون.
تقييم الفعالية المضادة للجراثيم للببتيد المؤشب
تم تقييم النشاط المضاد للجراثيم للببتيد المؤشب من نوع الإيومينتين باستخدام اختبار كيربي-باور ضد أربع سلالات جرثومية معيارية الجدول (2). أظهرت النتائج أن الببتيد المؤشب أحدث مناطق تثبيط واضحة في السلالتين إيجابيتَي الغرام ، حيث بلغ متوسط قطر منطقة التثبيط ضد S.aureus 17.3 ± 0.5 مم، وكان L.monocytogenes 15.9 ± 0.7 مم الشكل (7). أما في السلالات سلبية الغرام، فقد لوحظ نشاط مضاد للميكروبات ولكن بدرجة أقل، حيث بلغ متوسط قطر منطقة التثبيط ضد S. enterica 11.2 ± 0.6 مم، وضد Y. enterocolitica 10.5 ± 0.8 مم، مع تسجيل بعض حالات النمو الجزئي قرب حدود مناطق التثبيط.
الشكل (7): تقييم الفعالية المضادة للجراثيم للببتيد المؤشب Eumen-sfGFP ضد Listeria monocytogenesباستخدام اختبار كيربي-باور تُظهر الصورة مناطق تثبيط واضحة: (A) ببتيد عياري (C) المحمّل بالببتيد المؤشب (B) والشاهد السلبي محلول دارئة فقط(D) المضاد الحيوي المرجعي كاربنسيلين.
أظهرت مقارنة الفعالية أن الببتيد المؤشب حافظ على مستوى مقارب للببتيد النقي التجاري (Novoprolabs)، حيث كانت فروق أقطار مناطق التثبيط غير معنوية إحصائيًا (P > 0.05) في معظم السلالات. في المقابل، أعطت الأقراص المحمّلة بالمضادات الحيوية المرجعية (كاربنسيلين أو فانكومايسين) مناطق تثبيط أكبر تراوحت بين 20.1 ± 0.9 مم و23.4 ± 1.1 مم. أما أقراص الشاهد السلبي (محلول الدارئة فقط) فلم تُظهر أي منطقة تثبيط، مما يشير إلى أن النشاط المضاد يعود حصريًا للببتيد. جدول (2).

المناقشة Discussion
أظهرت نتائج التعبير الجيني والتعبير البروتيني لببتيد Eumenitin-sfGFP نجاحًا كاملاً في إنتاج النسخة المؤشبة باستخدام نظام التعبير في Escherichia coli. تم تأكيد صحة الإدخال الجيني من خلال تحليل تفاعل البوليميراز المتسلسل (PCR) وتوافق التسلسل بنسبة 100% مع التسلسل المصمم، مما يدل على دقة التصميم وخلو البنية البلازميدية من الطفرات [14]. ويُعد نظام E. coli من الأنظمة المُفضلة في التعبير البروتيني نتيجة لمعدل نموه السريع، وانخفاض تكاليف زراعته، وسهولة التلاعب الجيني به [17]. عُزي ظهور العصابة البروتينية عند ~38 كيلودالتون إلى البنية المؤشبة المصممة، في حين أن الوزن الجزيئي النظري للبروتين المؤشّب (Eumenitin + sfGFP + His-tag + linker) يُقدَّر بـ ~31 كيلودالتون استنادًا إلى تسلسل الأحماض الأمينية والتي تتكوّن من الببتيد Eumenitin 1645 دالتون، مع البروتين الفلوري sfGFP 27500 دالتون، إضافةً إلى وصلة مرنة وتسلسل His-tag.. يُعزى هذا الاختلاف بين الوزن المتوقع والملاحظ إلى طبيعة البروتين المؤشّب وارتباطه بالبروتين الفلوري الأخضر (sfGFP)، إذ يمكن أن تؤدي التغيرات في طي البروتين أو شحنته الكهربية إلى إبطاء هجرته في هلام SDS-PAGE فيظهر بوزن أعلى من الحسابات النظرية. وقد وثّقت دراسات سابقة هذه الظاهرة عند دمج ببتيدات قصيرة أو مضادة للميكروبات مع GFP، حيث بقيت البروتينات المؤشّبة مستقرة وفعّالة دون أن يؤثر ذلك سلبًا على التعبير أو القابلية للذوبان [[18,19 حُدد تركيز البروتين المنقى باستخدام اختبار Bradford138.83 ميكروغرام/مل.
تتفق هذه النتائج مع دراسات سابقة أثبتت إمكانية دمج ببتيدات فعالة حيويًا ضمن بروتينات مؤشّبة دون التأثير السلبي على عملية التعبير أو القابلية للذوبان فقد أظهرت دراسة لـ Glukhova وآخرين أن دمج ببتيد مضاد للميكروبات ضمن التركيب الأسطواني لبروتين GFP أنتج تركيبًا مستقرًا وقابلًا للذوبان، مما يُشير إلى إمكانية استخدام GFP كإطار حامل للببتيدات النشطة [18]. و كمثال آخر أظهرت دراسة Zhang et al. أن ببتيد CAMA-syn المؤشب و المدمج مع GFP احتفظ بفعاليته المضادة للبكتيريا عند التعبير به في خلايا ثديية [19].
في تقييم النشاط المضاد للميكروبات، أظهر الببتيد المؤشب فعالية يعتد بها، خاصةً ضد الجراثيم إيجابية الغرام، وهو ما يتماشى مع الخصائص البنيوية لببتيد Eumenitin، المصنف كببتيد كاتيوني حلزوني (α-helical amphipathic peptide) يُعتقد أن آليته تعتمد على التفاعل الكهرساكني مع الأغشية الغنية بالشحنات السالبة، مما يؤدي إلى اختلال نفاذية الغشاء أو تكوين مسام [20,21]. توافقت دراستنا مع دراسة سابقة مثل دراسة Konno et al. أن Eumenitin يُكوّن بالفعل مسامًا صغيرة انتقائية للأيونات في الأغشية الصناعية، ما يفسر تأثيره المباشر على الأغشية البكتيرية دون إحداث انحلال خلوي [10]. أما الانخفاض النسبي في الفعالية ضد السلالات سالبة الغرام، فيُعزى إلى طبيعة غشائها الخارجي المعقّد الذي يقيها جزئيًا من اختراق الببتيدات [22].
من اللافت أن الببتيد المؤشب احتفظ بفعالية مشابهة للببتيد النقي التجاري، حيث لم تسجل فروق معنوية في أقطار التثبيط في معظم السلالات المختبرة. تؤكد هذه النتائج أن دمج الببتيد مع بروتين sfGFP لم يؤثر على النشاط الحيوي، وهو ما يتماشى مع تقارير سابقة تشير إلى خمول GFP حيويًا وعدم تدخله في التأثيرات المضادة للميكروبات [23]. كما أن استخدام GFP يوفر ميزة إضافية في تتبع التعبير والتحقق من الطي البروتيني الصحيح [24,25].
يجدر التنويه إلى أن اختبار كيربي-باور (Kirby–Bauer disk diffusion)، رغم شيوعه في تقييم فعالية المضادات الحيوية، لا يُعد الطريقة المثلى لتقييم الببتيدات المضادة للميكروبات، نظرًا لمحدودية انتشار هذه الجزيئات الصغيرة والمشحونة في وسط الآغار. وبالتالي، فإن النتائج المستخلصة من هذا النوع من التجارب تُعد مؤشرات كيفية (نوعية) أولية وليست قياسات كمية دقيقة. توصي الأدبيات باستخدام اختبارات تعتمد على الأوساط السائلة مثل التركيز المثبط الأدنى (Minimum Inhibitory Concentration; MIC) والتركيز القاتل الأدنى (Minimum Bactericidal Concentration; MBC)، لتوفير تقدير كمي أكثر دقة للفعالية الحيوية للببتيد.
تُعد محدودية استخدام اختبار كيربي–باور مع الببتيدات قصيرة السلسلة أحد القيود المنهجية في هذه الدراسة، إلى جانب غياب التقييم الكمي بواسطة اختبارات التركيز المثبط الأدنى (MIC) والقاتل الأدنى (MBC)، فضلاً عن عدم إجراء تقييمات حيوية داخل الجسم الحي (in vivo). يُوصى بمعالجة هذه الجوانب كما يُوصى بتعزيز النتائج باستخدام عيارات إضافية مثل اختبار بروتين GFP لوحده للتأكد من خلوه من النشاط المضاد للجراثيم، واختبار الببتيد المؤشَّب مع كريات دم بشرية في مستنبت خلوي لإثبات عدم سميته. كما يُستحسن فصل البنية الوظيفية للببتيد عن بروتين التتبع GFP باستخدام وصلة إنزيمية قابلة للقطع مثل TEV linker، بما يسمح بتقييم النشاط الحيوي للببتيد بصيغته النقية والمستقلة.
بناءً على ما سبق، يُعد التصميم المؤشّب Eumenitin-sfGFP نموذجًا واعدًا لإنتاج ببتيدات فعالة حيويًا بطريقة مستقرة وقابلة للتتبع، مع الحفاظ على نشاطها المضاد للميكروبات. وتشير الأدبيات إلى أن Eumenitin يتمتع بملف أمان حيوي جيد، مما يعزز من إمكانياته كمرشح علاجي محتمل في ظل تزايد مقاومة المضادات الحيوية.
تُظهر هذه الدراسة أن دمج الببتيد الحيوي Eumenitin ببروتين sfGFP لم يؤثر على نشاطه المضاد للميكروبات، مما يدعم جدوى هذا التصميم لتطوير أنظمة تتبع بصرية أو دمجه في صيغ دوائية مستقبلية. كما يُوصى في الأبحاث اللاحقة بفصل الببتيد عن بروتين التتبع باستخدام وصلة إنزيمية قابلة للقطع مثل TEV linker للحصول على نسخة نقية للتقييم الحيوي المستقل.
أكد نظام التعبير المعتمد في E. coli كفاءته في إنتاج البروتين المؤشب بكميات جيدة ونقاء عالٍ وبتكلفة منخفضة، مما يجعله منصة مناسبة لإنتاج الببتيدات الحيوية [26]. توصي الدراسة بإجراء اختبارات كمية أكثر دقة (مثل MIC وMBC) وتوسيع التقييم ليشمل دراسات داخل الجسم الحي (in vivo)، بهدف استكمال التوصيف الحيوي والتحقق من إمكانيات Eumenitin كمضاد ميكروبي واعد في مواجهة مقاومة المضادات الحيوية.
قائمة الاختصارات List of abbreviations
| الاختصار | اللغة العربية | اللغة الإنكليزية |
| AMP | ببتيد مضاد للميكروبات | Antimicrobial Peptide |
| BSA | ألبومين مصل البقر | Bovine Serum Albumin |
| CFU | وحدة تشكيل مستعمرة | Colony Forming Unit |
| CLSI | معهد المعايير السريرية والمخبرية | Clinical and Laboratory Standards Institute |
| DNA | الحمض النووي الريبوزي منقوص الأكسجين | Deoxyribonucleic Acid |
| E. coli | الإشريكية القولونية | Escherichia coli |
| GFP | البروتين الفلوري الأخضر | Green Fluorescent Protein |
| His-tag | وسمة الهيستيدين | Histidine Tag |
| IMAC | كروماتوغرافيا الإلفة المعدنية | Immobilized Metal Affinity Chromatography |
| IPTG | أيزوبروبيل ثيو-β-D-جالاكتوزيد | Isopropyl β-D-1-thiogalactopyranoside |
| LB | وسط لوريا-بيرتاني | Luria-Bertani medium |
| MBC | التركيز القاتل الأدنى | Minimum Bactericidal Concentration |
| MIC | التركيز المثبط الأدنى | Minimum Inhibitory Concentration |
| Ni-NTA | راتنج نيتريلوتري أسيتيك النيكل | Nickel-Nitrilotriacetic Acid |
| PCR | تفاعل البلمرة المتسلسل | Polymerase Chain Reaction |
| SDS-PAGE | الرحلان الكهربائي للهلام بولي أكريلاميد مع SDS | Sodium Dodecyl Sulfate Polyacrylamide Gel Electrophoresis |
| sfGFP | البروتين الفلوري الأخضر الفائق | Superfolder Green Fluorescent Protein |
| SPSS | الحزمة الإحصائية للعلوم الاجتماعية | Statistical Package for the Social Sciences |
| WHO | منظمة الصحة العالمية | World Health Organization |
تضارب المصالح Conflict of interests
يُقرّ جميع الباحثين المشاركين في هذا البحث بعدم وجود تضارب في المصالح فيما بينهم.
Funding التمويل
مُوِّل هذا البحث جزئيًا من قبل جامعة دمشق وتحمّلت الباحثة جميع التكاليف الأخرى.
الشكر والتقدير Acknowledgements
اتقدم بخالص الشكر والامتنان إلى هيئة الطاقة الذرية السورية – قسم البيولوجيا الجزيئية والتقانة الحيوية، وعلى رأسها الدكتور أنطونيوس الداود، رئيس القسم، لما قدموه من دعم علمي وتقني، وتوفير الإمكانات والتسهيلات التي ساهمت في تنفيذ هذا البحث. وأعرب عن بالغ التقدير والامتنان لـلدكتور عبد القادر عبادي على توجيهاته العلمية القيّمة، ومتابعته الدقيقة لمراحل العمل، وإلى الدكتور أيمن المريري على ما قدمه من دعم وإتاحة الفرصة للانخراط في هذا المجال البحثي.
المراجع :26 .Li Y. Recombinant production of antimicrobial peptides in Escherichia coli: a review. Protein Expr Purif. 2011;80(2):260-7. doi:10.1016/j.pep.2011.08.001.